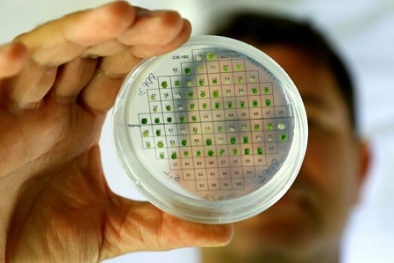
Sản xuất điện từ thực vật: Chuyện thật hay đùa?

Thương hiệu Hội nhập
Công nghệ

Đổi mới sáng tạo – động lực từ toàn dân đến quốc gia
(VietQ.vn) - Đổi mới sáng tạo ở Việt Nam không chỉ là nhiệm vụ của doanh nghiệp hay các nhà khoa học, mà đã trở thành phong trào toàn dân. Khi cả cộng đồng cùng chung tay, đổi mới sáng tạo được lan tỏa thành lối sống, mở ra động lực để đất nước bứt phá.
-

BMW series 5 2021: Dùng iphone thay cho thìa khóa ô tô
Realme C11 lộ diện, sử dụng chip MediaTek Helio G35, màn hình lớn 6,5 inch
iOS 14 ra mắt với nhiều tính năng mới, hé lộ điều thú vị kết hợp cùng đối tác BMW
Thủ thuật khắc phục điện thoại tự khởi động lại liên tục
Tạo ra vật liệu thông minh giúp đường cao tốc có thể 'tự sửa chữa' khi hư hỏng
Chỉ 25 phút test nước bọt đã phát hiện virus SARS-CoV-2
Thuốc alpha-ketoamide 13b có khả năng chặn đứng việc nhân bản virus SARS-CoV-2
-

Đổi mới sáng tạo: Từ 'bài toán khó' của đất nước thành 'cơ hội mới' cho tương lai
-

Nhiều bệnh viện lớn bị tấn công mạng, dữ liệu bệnh nhân bị rao bán trên diễn đàn hacker
Tin mới Công nghệ 24h

Thủ thuật khắc phục máy tính tự tắt khi xem video
(VietQ.vn) - Nếu trong khi đang xem video trên máy tính tự dưng gặp phải trường hợp máy tính đột nhiên bị tắt nguồn thì người dùng cũng không nên lo lắng bởi thủ thuật khắc phục khá đơn giản.

Việt Nam chia sẻ kinh nghiệm ứng dụng công nghệ hạt nhân trong ứng phó dịch COVID-19
(VietQ.vn) - Việt Nam là một trong những quốc gia đầu tiên phát hiện các trường hợp bị COVID-19 và đã đạt một số thành công trong ứng phó với dịch bệnh này.

Đưa sở hữu trí tuệ thành công cụ phục vụ phát triển kinh tế - xã hội
(VietQ.vn) - Bộ trưởng Chu Ngọc Anh đánh giá cao vai trò của Cục Sở hữu trí tuệ trong việc đưa sở hữu trí tuệ trở thành công cụ phục vụ khoa học và công nghệ, đổi mới sáng tạo cũng như phát triển kinh tế- xã hội của đất nước.

'Đánh cắp' nội dung từ TikTok, một ứng dụng bị xóa khỏi kho của Android và iOS
(VietQ.vn) - Zynn, một ứng dụng trả tiền cho người xem video đã bị gỡ khỏi kho ứng dụng của Android và iOS do 'đánh cắp' nội dung từ TikTok.

Ứng dụng điện thoại thông minh phát hiện suy tim thông qua giọng nói người dùng
(VietQ.vn) - Triệu chứng phổ biến nhất của suy tim là khó thở do chất lỏng tích tụ trong phổi. Một ứng dụng mới được phát triển từ ý tưởng này, có khả năng cứu sống người vì nó phân tích giọng nói của người dùng để xem liệu họ có đang bị tắc nghẽn phổi liên quan đến suy tim hay không.

Thủ thuật khắc phục màn hình máy tính bị nhiễu tưởng khó mà dễ
(VietQ.vn) - Nếu gặp phải trường hợp màn hình máy tính bỗng dưng bị lỗi người dùng không nên vội đánh đồng lỗi thuộc về hãng sản xuất, hãy bình tĩnh tìm hiểu nguyên nhân, cách khắc phục?

Công nghệ sẽ giúp báo chí thay đổi và ngày càng hoàn thiện hơn
(VietQ.vn) - “Công nghệ sẽ tạo ra cuộc chơi mới, mô hình kinh doanh mới, trong bối cảnh hệ sinh thái truyền thông số trên toàn thế giới đang có những biến động rất mạnh, đặt cho báo chí trước hoàn cảnh khốc liệt để tồn tại, phát triển...”, ông Nguyễn Mạnh Hùng - Bộ trưởng Bộ thông tin và Truyền thông nhấn mạnh.

Xuất hiện loại khẩu trang đặc biệt tiêu diệt Sars-Cov-2 bằng nhiệt
(VietQ.vn) - Các nhà nghiên cứu Israel vừa phát minh ra một loại khẩu trang có thể diệt virus Sars-Cov-2 gây bệnh viêm đường hô hấp cấp COVID-19 bằng nhiệt.

Thủ thuật khắc phục laptop bị giật màn hình đơn giản, hiệu quả
(VietQ.vn) - Một khi laptop bị giật màn hình sẽ ảnh hưởng không nhỏ tới quá trình làm việc. Khi gặp trường hợp này người dùng cần bình tĩnh để tìm cách tự khắc phục tại nhà, tránh mất tiền sửa chữa.
Sản xuất điện từ thực vật: Chuyện thật hay đùa?
(VietQ.vn) - Các nhà khoa học Israel và Mỹ vừa hợp tác sản xuất thành công khí hydro từ tảo, mở ra hy vọng tạo điện từ thực vật trong tương lai.

Thủ thuật khắc phục phục lỗi màn hình máy tính bị đen trên Windows 10
(VietQ.vn) - Khi màn hình máy tính bị đen là lỗi không thường xuyên xảy ra nên một khi gặp phải sẽ khiến nhiều người lo lắng. Thực tế đây là lỗi khó khắc phục nhưng sẽ đơn giản nếu thực hiện theo chuẩn hướng dẫn của các chuyên gia công nghệ.

3 nhà khoa học nữ Việt Nam lọt top 100 nhà nghiên cứu tiêu biểu châu Á năm 2020
(VietQ.vn) - Tạp chí Asian Scientist (Singapore) vừa công bố kết quả bình chọn 100 nhà nghiên cứu tiêu biểu châu Á năm 2020. Việt Nam có 3 nhà khoa học nữ được vinh dự bình chọn.

Video, cơ sở hạ tầng và chuyển đổi số sẽ 'chuyển mình' sau đại dịch Covid-19
(VietQ.vn) - Đại dịch Covid-19 gây ra những thay đổi lớn trong các phân khúc chính từ dịch vụ trực tuyến, chi phí đầu tư, điện toán đám mây cho đến chuỗi cung ứng điện tử.

Số trạm sạc công cộng tăng 60% và tương lai ngành xe điện toàn cầu
(VietQ.vn) - Cơ quan Năng lượng quốc tế (IEA) cho biết, số lượng điểm sạc xe điện công cộng trên toàn cầu tăng 60% trong năm 2019, mức tăng lớn nhất trong 3 năm qua và vượt xa doanh số bán xe.

Ứng dụng chỉnh sửa video nổi tiếng có thể đang âm thầm đánh cắp thông tin người dùng
(VietQ.vn) - Ứng dụng chỉnh sửa video nổi tiếng VivaVideo bị các chuyên gia nhận định đang yêu cầu truy cập quá nhiều thông tin riêng tư không cần thiết, gây nhiều nguy hiểm khó lường cho người sử dụng.

Báo chí đồng hành, góp phần đưa thông tin KH&CN đến gần hơn với công chúng
(VietQ.vn) - Thời gian qua, báo chí mà cụ thể là đội ngũ phóng viên, biên tập viên, nhà báo khắp cả nước đã tích cực tham gia tuyên truyền về KH&CN, truyền tải những nội dung vốn rất khô cứng đến đông đảo bạn đọc. Nhiều thành tựu nghiên cứu cũng được truyền thông rộng rãi, góp phần nâng cao nhận thức của người dân về vai trò của KH&CN...

Thủ thuật khắc phục lỗi không kết nối được wifi trên điện thoại iPhone
(VietQ.vn) - Trong khi sử dụng điện thoại iPhone không ít lần người dùng gặp trường hợp điện thoại không thể kết nối được wifi. Thực chất đây là lỗi thường gặp nên có rất nhiều thủ thuật khắc phục hiệu quả.

IBM ngừng cung cấp công nghệ nhận dạng khuôn mặt?
(VietQ.vn) - Giám đốc điều hành International Business Machines Corp (IBM), ông Arvind Krishna cho biết họ sẽ không còn cung cấp phần mềm phân tích hoặc nhận dạng khuôn mặt cho mục đích chung.

Thủ thuật khắc phục lỗi điện thoại không gọi đi được
(VietQ.vn) - Điện thoại là thứ để liên lạc nhưng bất ngờ không thể gọi được vì một lỗi nào đó gây bất tiện cho người dùng. Vậy đâu là nguyên nhân và thủ thuật khắc phục đơn giản nhất?

Chiến lược quốc gia về SHTT của Việt Nam sẽ là ví dụ tốt cho nhiều nước học tập
(VietQ.vn) - Tân Tổng Giám đốc WIPO cho rằng việc Việt Nam ban hành Chiến lược quốc gia về SHTT sẽ là ví dụ tốt cho nhiều nước học tập kinh nghiệm.





